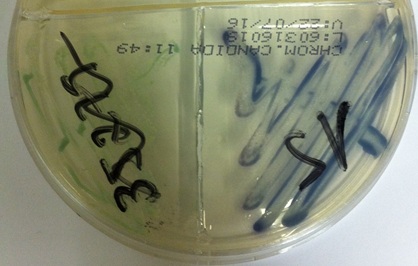

Revisão de Micologia
Filamentosos
Dermatófitos:
- · Trichophyton rubrum
Exame direto: artroconídeos; Colônia: Roxa;
Urease: negativa; Hifa comprida e contínua, microconídeos.
- · Trichophyton mentagrophytes
Exame direto: artroconídeos; Colônia: creme; Urease:
positiva;
- · Microsporum canis
Exame
direto: artroconídeos; Colônia: laranja; Hifa retilínea, clamidoconídio.
- · Microsporum gypseum
Exame direto: artroconídeos; Colônia: café
com leite; Hifa retilínea, muitos macroconídeos.
Filamentosos:
- · Fusarium solani
Exame direto: fragmentos de hifas; Colônia:
Ágar batata (creme) Ágar Sabouraud (roxo); Microconídeos;
- · Aspergillus fumigatus
Exame direto: hifa dicotômica em ângulo de
45ºC; Colônia: verde com borda branca.
- Aspergillus flavus
Exame direto: hifa dicotômica em ângulo de
45ºC; Colônia: verde com borda branca.
Leveduras:
- · Malassezia furfur
Sinal de Zireli
- · Trichosporon asahii
Galactomanana: negativo; Blastoconídeo e
artroconídeo.
- · Cryptococcus sp
- · Candida albicans
Colônia verde
- · Candida tropicalis
Colônia azul